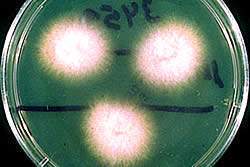

Mal de Panamá
| ||||
Mal de Panamá. Se le conoce con ese nombre a la enfermedad de marchitamiento en los plátanos y bananos producida por el hongo Fusarium oxysporum f. sp. cubense. Se trata de una de las amenazas, de extensión internacional, más graves de las plataneras y causante de cuantiosas pérdidas económicas. Este patógeno, que ataca las raíces e invade el sistema vascular de la platanera, impide su normal alimentación y ocasiona una progresiva deshidratación, amarillamiento de la hoja, marchitez y, por fin, la muerte de la planta.
Sumario
Sinónimos
Fusarium cubense.
Otro nombre común
Marchitez de los plátanos.
Nombre en inglés
Panama disease, Fusarium wilt.
Distribución e importancia
Este patógeno está presente en todo el territorio nacional, pero no constituye un peligro para los clones que en la actualidad están establecidos. La capacidad de persistir por mucho tiempo en el suelo le confiere importancia para algunos clones, como burro tradicional y otros. Se conoce como patógeno solo de especies de Musa.
Taxonomía
- Reino: Fungi
- División: Ascomycota
- Clase: Sordariomycetes
- Orden: Hypocreales
- Familia: Nectriaceae
- Género: Fusarium
- Especie: Fusarium oxysporum f. sp. cubense W.C. Snyder & H.N. Hansen
Biología
Es un saprofito facultativo que vive en el suelo y penetra en la planta, directa o indirectamente, a través de las raíces y los rizomas, luego produce micelios intercelulares que avanzan hacia arriba por el tronco y las hojas a través de los haces vasculares.
Facilitan su penetración las heridas producidas en las raíces (por las labores y los nematodos), la asfixia radicular por exceso de agua, etc.
A los dos meses aproximadamente de la infección de las raíces aparecen los primeros síntomas de marchitez. La diseminación de las conidias del patógeno se efectúa a través del aire, mediante el agua de riego y del movimiento del suelo infestado.
La infección y desarrollo de la enfermedad depende de la resistencia varietal, edad de las plantaciones y la intensidad de crecimiento del cultivo. Favorecen su desarrollo ciertos desequilibrios de N, P y K, altos contenidos de fósforo en el suelo y los bajos contenidos de zinc y de materia orgánica.
Síntomas y daños
El primer síntoma que normalmente se aprecia es un amarillamiento de las hojas inferiores, desde el borde hacia el nervio central. Puede ocurrir que algunas de las hojas jóvenes interiores sean las primeras en presentar síntomas de decoloración.
Las hojas descoloridas se marchitan rápidamente, los peciolos se encorvan y las hojas cuelgan y toman un color pardo, formando una agrupación alrededor del pseudotallo y la planta muere.
Los racimos se desarrollan de forma anormal, los frutos maduran prematura e irregularmente, adquieren forma de cuello de botella y la pulpa se torna esponjosa, amarga y amarilla. Los haces vasculares de las plantas presentan coloraciones amarillas, rojas o pardas y los rizomas enfermos emiten un olor característicamente desagradable debido a las pudriciones.
Medidas de control
Agrotécnicas
- Selección de suelos con buen drenaje superficial e interno.
- Utilización de clones de plátanos y bananos resistentes a las razas presentes (como las del grupo Cavendish, Burro CEMSA y FHIA 03).
- Uso de material de plantación libre de la enfermedad.
- Mantenimiento de una adecuada nutrición del cultivo y no utilizar materia orgánica elaborada con material contaminado.
- Aportar de 1 a 2 Kgrs/planta de hidróxido cálcico a aquellas plantas que ya han manifestado los síntomas para evitar la dispersión del inoculo y provocar una subida brusca del pH que dificulte el desarrollo del hongo.
Plantar en suelos que no alberguen la enfermedad en ese momento, o en caso de existir antecedentes de plantas afectadas, no realizar movimientos de tierra en las zonas donde se hayan detectado plantas enfermas.
- Realizar enmiendas al suelo si fuese
necesario, principalmente aportando calcio a unos niveles adecuados (entre 1 y 2 Kgrs/planta de yeso agrícola o tiosulfato cálcico a los niveles adecuados).
- No deshijar aquellas plantas afectadas hasta el verano, para evitar el periodo de máxima incidencia y procurando que en esta labor se rompan las mínimas raíces, además de desinfectar la barreta con lejía después de cada uso.
- Aumentar el contenido en materia orgánica en el suelo, por niveles por encima del 3 % como mínimo.
Biológicas
Se debe procurar el tratamiento a las posturas en bolsas antes del transplante con el antagonista Trichoderma harzianum (cepa 34), para que el mismo se establezca en el campo definitivamente.
Química
- Empleo de PARAM-A
Una serie de compuestos inocuos para las personas, los animales, las plantas y el medio ambiente, que en condiciones de campo han demostrado una contrastada eficacia en la lucha contra el mal de Panamá de la platanera. Esta enfermedad no tenía hasta la fecha posibilidades de control químico.
Se ha comprobado que las plantas pretratadas con estos compuestos biosintetizan diferentes cantidades de antibióticos de defensa (fitoalexinas) que las plataneras control cuando se someten a inoculación en las mismas condiciones experimentales.
En realidad, lo que realmente ocurre es que las plantas pre-tratadas con estos compuestos naturales imitan al modelo de interacción incompatible (resistente) platanera-hongo.
Dado que este tipo de compuestos no actúan directamente contra el patógeno sino a través de la planta, reforzando sus defensas, se han iniciado ya investigaciones con objeto de probar su eficacia en otros sistemas planta-parásito, habiéndose obtenido resultados muy prometedores en experiencias preliminares efectuadas en diversos cultivos. En contraste con los pesticidas este tipo de sustancias no contaminantes están llamadas a desempeñar un importante papel en la agricultura en los próximos años.
Enlaces internos
Fuentes
Martínez González, E.; Barrios Sanromá G.; Rovesti L. y Santos Palma R. Manejo Integrado de Plagas. Manual Práctico. Centro Nacional de Sanidad Vegetal (CNSV), Cuba,2006.